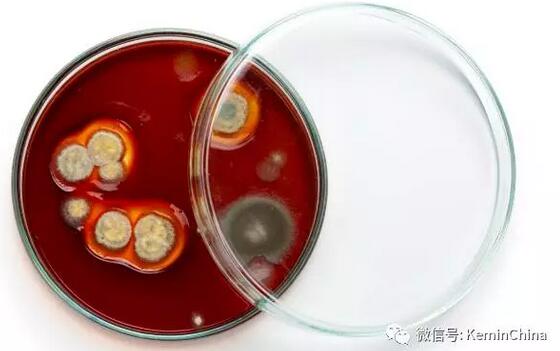

益生菌评估要根据产品特点而定
文:罗正 建明工业(珠海)有限公司
文:罗正 建明工业(珠海)有限公司
随着大家对益生菌的认识不断深入,以及一些国家强制性要求抗生素替代需求,益生菌越来越成为饲料添加剂中改善肠道健康,替代抗生素的重要组成部分。因此,饲料企业、养殖场评估益生菌/微生态制剂的有效性显得格外重要。
共同梳理益生菌的种类,学习不同种类益生菌的基本特点,也是我们行业人士需要做的。
1 国家规定及新增的微生物菌种
2013年我国农业部第2045号公告饲料添加剂品种目录中规定了34个菌种可用作动物微生物饲料及饲料添加剂,比2008年农业部1126号公告的16个菌种增加18个菌种,菌种丰富度显著增加,但是与美国FDA规定的42个菌种相比还少8种。分析新的微生物饲料添加剂的菌种可以发现大致包含3大类菌,分别是芽孢杆菌类、乳酸菌类及真菌类(酵母和曲霉菌)。建明出品。从增加的菌种分类来看最多的是乳酸菌属。
2 芽孢杆菌类的特点

2)能产生消化酶帮助宿主进行营养物质消化吸收。
3)能产生抑菌物质,减少有害菌对动物倡导的侵害,目前已有很多关于枯草芽孢杆菌抑菌替代抗生素的文章发表。
4)刺激肠道,激活免疫系统,提高对疾病的抵抗能力。
3 乳酸菌类的特点
1)耐酸性强,在pH值3.0-4.5条件下可以生长,能顺利通过胃进入到肠道中生长。
2)乳酸菌不耐高温是公认的问题,在80℃条件下5分钟大部分的菌体会死亡,对于制粒饲料乳酸菌的应用受到极大的限制。
3)定殖能力强,不需要长期使用,这也是为什么在正常动物肠道中存在大量的乳酸菌的重要原因。建明出品。
4)产生有益成分,乳酸是他们最重要的产物,有益于肠道健康,不仅如此他们还能产生类似维生素类的有益物质,能促进动物生长。
4 真菌类的特点
2)含有丰富的脂肪、蛋白、维生素等营养成分,能够增加饲料的营养和适口性,促进动物采食。
3)酵母细胞壁不能被动物消化吸收,但是可以被有益菌利用,改善肠道健康。
4)调剂动物机体免疫能力。

